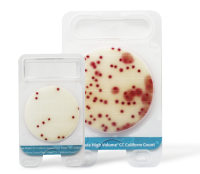
大肠杆菌/大肠菌群检测片

相关产品推荐更多 >
万千商家帮你免费找货
0 人在求购买到急需产品
- 详细信息
- 文献和实验
- 技术资料
Evergreen呕吐毒素(DON)检测试剂盒可定量检测粮食、谷物和其他农产品及饲料等样品中脱氧雪腐镰刀菌烯醇的含量。 检测原理Evergreen脱氧雪腐镰刀菌烯醇(DON)检测试剂盒采用固相直接竞争性酶联免疫原理检测样品中的脱氧雪腐镰刀菌烯醇。微孔中包被有脱氧雪腐镰刀菌烯醇的特异性抗体,标准品或样品中的DON与DON酶标物竞争结合微孔中的抗体。孵育一定时间后,倾倒微孔中的内容物并通过洗涤去除非特异反应物。然后向微孔中加入酶底物(TMB),溶液变为蓝色。颜色强度与与DON酶标物的浓度成正比,与标准品或样品中DON的浓度成反比。最后加入终止液,颜色由蓝色转变为黄色。使用酶标仪在450nm下检测微孔中溶液的OD值。比较样品OD值与试剂盒提供的标准品的OD值,即可得出结果。
|
|
|||||||||||||||||||||||||||
试剂盒组成(注:试剂盒2-8℃保存,不要冷冻)
订货信息
|
||||||||||||||||||||||||||||
风险提示:丁香通仅作为第三方平台,为商家信息发布提供平台空间。用户咨询产品时请注意保护个人信息及财产安全,合理判断,谨慎选购商品,商家和用户对交易行为负责。对于医疗器械类产品,请先查证核实企业经营资质和医疗器械产品注册证情况。
文献和实验Gene Knockout Techniques(1) The Knockout Process
to save time and materials, but everything can be done in 96-well plates if you don?t have access to 384-well equipment. 10 ul reactions work fine in 96-well plates, and don?t require nearly as much Taq. To date we have done most steps with worms grown on solid
好消息--PeproTech ELISA操作指南视频已上传!
美国 PeproTech ( 派普泰克 ) 公司是世界上领先的重组细胞因子和蛋白生产商,同时也生产多种细胞因子和蛋白的 ELISA 法检测试剂盒,详细信息请查看 www.peprotech.com ,或与 PeproTech 中国代表处 ( 电话: 0512-6832 5993 , Email : china@peprotechasia.com ) 联系。 为让中国用户能够更好的熟悉和掌握 PeproTech 的 ELISA 试剂
酶联免疫检测技术的应用 真菌毒素的检测:黄曲霉毒素 B 1 、 M 1 以及 T-2 毒素,脱氧雪腐镰刀菌烯醇(呕吐毒素 DON ),二乙酰草镰刀菌烯醇( DAS ),玉米赤霉烯酮,赫曲霉毒素 A ( OA )。 农药的检测:主要有除草剂与杀虫剂两大类,例如杀暝松( FN )、甲氟磷酸异已酶( SOMAN )、草不绿( Alachor )、西维因( Carbaryl )、多菌灵及克菌丹( Captan )等。 其他类的检测:盐酸克伦特罗,河豚毒素,植物毒素如�粟硷
技术资料暂无技术资料 索取技术资料